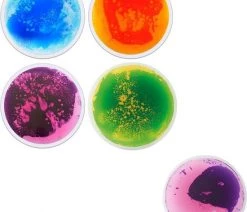
Eduplay Sensory Vloertegels Rond 6 Eduplay Sensory Vloertegels Rond -Vloerspellen Verkoop 550x590 1

Prachtig kleurrijk en fantasierijke patronen, deze tegels hebben het.
De tegels zijn zeer stevig en gevuld met cosmetische vloeistof (niet giftig).
Ze hebben een antislip bodem en de 3,5 mm dikke beschermingslaag is bijzonder bestand tegen krassen en slijtage.
Elke tegel is belastbaar tot 90 kg.
Voor de bevordering van coördinatie en evenwicht kan men op één been staan, langzaam verplaatsen van het ene naar het andere been, met één teen op de mat tikken of doorzakken op één been.
En natuurlijk gewoon plezier beleven met de felgekleurde tegels.
Specificaties
5 matten in de kleuren oranje, blauw, roze, paars, groen.
Gewicht: ca. 11 kg / m².
Brandbeveiliging: EN13501-1: 2007 Lf1-S1.
Niet ontvlambaar
Recyclebaar
Materiaal: PVC, PE, water met gekleurde cosmetische vloeistof (niet giftig)
Afmetingen: Ø 40 x 40 cm, 7,5 mm dik, waarvan 2 mm anti-sliplaag
Kleuren kunnen ietwat afwijken van de foto

Beoordelingen
Er zijn nog geen beoordelingen.